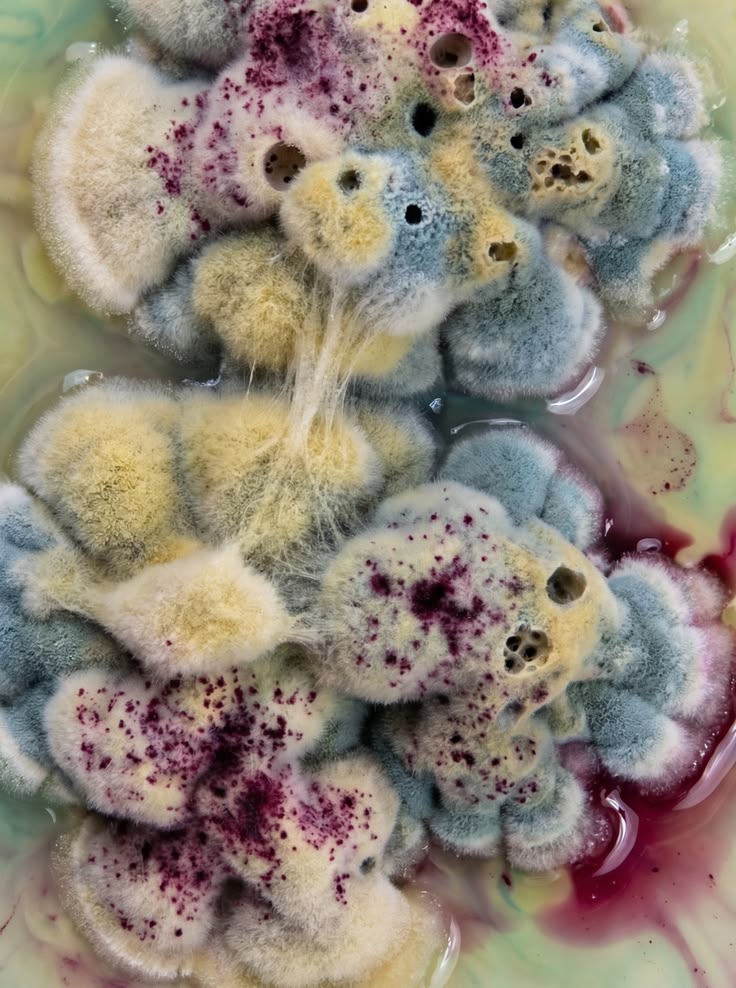
For all Curious tweet media

In this episode of the Bitmap series, we explore the potential upside of Bitmap given its unique composition. Jason Cassidy explains the various benefits of being a Bitmap holder and how to take advantage of them without breaking the bank. 👉 Check out the full episode link in the thread below. @FollowJay #bitmap #bitcoin #ordinals #bitmapperks #cryptocollectibles #blockchain #digitalassets #bitcoinecosystem #tokenomics #cryptoinnovation